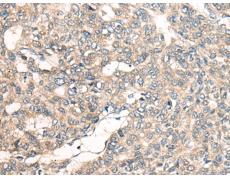
一抗

技術規(guī)格
|
Background: |
LRP1B belongs to the low density lipoprotein (LDL) receptor gene family. These receptors play a wide variety of roles in normal cell function and development due to their interactions with multiple ligands (Liu et al., 2001 [PubMed 11384978]). |
|
Applications: |
ELISA, IHC |
|
Name of antibody: |
LRP1B |
|
Immunogen: |
Synthetic peptide of human LRP1B |
|
Full name: |
LDL receptor related protein 1B |
|
Synonyms: |
LRPDIT; LRP-DIT |
|
SwissProt: |
Q9NZR2 |
|
ELISA Recommended dilution: |
5000-10000 |
|
IHC positive control: |
Human liver cancer |
|
IHC Recommend dilution: |
25-100 |

 購物車
購物車 幫助
幫助
 021-54845833/15800441009
021-54845833/15800441009